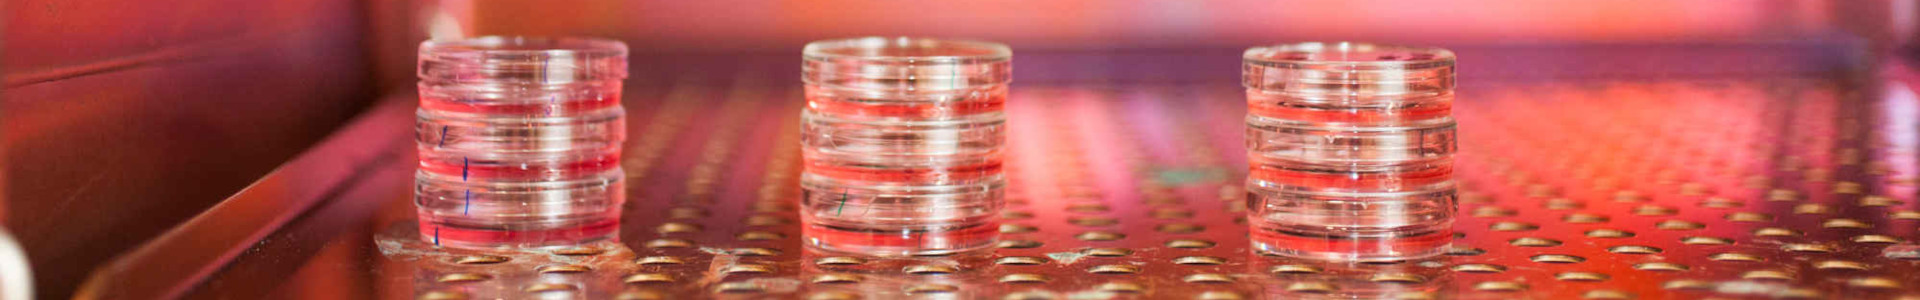

Center for Life Nano- & Neuro-Science
The center revolves around the neuroscience where technological innovation is key to reach the goals
The approach we use is strongly interdisciplinary, for a firm belief that a significant advancement in knowledge can be achieved only through the cooperation and close collaboration of researchers with deep disciplinary experience and a strong vocation for multidisciplinary dialogue. We supports and makes biologists, physicists, engineers, computer scientists and medical doctors talk to each other, with the aim of finding a common language that develops science and technology centered on mankind. It is on this peculiar ability to train "convergent" researchers, as well as on our scientific results, that the level of success of our center is measured.
Research Units
Center Coordinator
Nanotechnologies for Neurosciences
IIT OpenTalk Magazine - Center Highlights Show all >